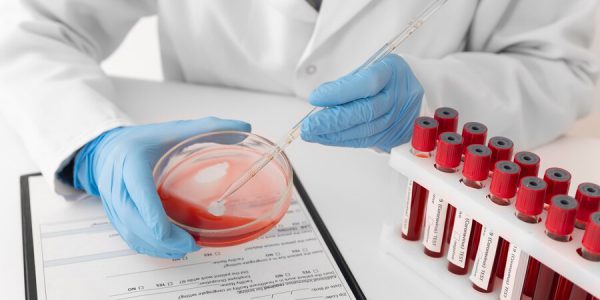

?️ Sağ Göz Seğirmesi Hangi Hastalığın Belirtisidir?
Sağ göz seğirmesi, birçok insanın zaman zaman deneyimlediği yaygın bir durumdur. Ancak bu durumun ardında yatan nedenler, kişiden kişiye değişebilir ve bazı sağlık sorunlarının habercisi olabilir. Bu yazıda, sağ göz seğirmesinin nedenlerini, olası hastalıkları ve hangi durumlarda doktora başvurmanız gerektiğini…
? Kumkuatın Faydaları Nelerdir?
Kumkuat, küçük, turuncu renkteki meyveleriyle dikkat çeken bir narenciye türüdür. Genellikle çiğ olarak tüketilen kumkuat, taze ve ekşi tatlarıyla damakları şenlendirir. Bu yazıda, kumkuatın sağlık üzerindeki faydalarını, besin değerlerini ve nasıl tüketilebileceğini ele alacağız. 1. Zengin Besin İçeriği Kumkuat, vitamin…
?⚕️ Reishi Mantarı Faydaları Nelerdir?
Reishi mantarı, özellikle Asya kültürlerinde “ölümsüzlük mantarı” olarak adlandırılan ve binlerce yıldır sağlık yararları için kullanılan bir bitkidir. Bu mantar, doğal bağışıklık güçlendirici özellikleriyle tanınır ve sağlık açısından birçok fayda sunar. İşte Reishi mantarının başlıca faydaları: 1. Bağışıklık Sistemini Güçlendirir…
? Pirinç Sabunu Faydaları Nelerdir?
Pirinç sabunu, Asya’nın geleneksel güzellik ritüellerinden biri olarak bilinir ve özellikle Japonya ve Kore’de sıkça kullanılmaktadır. Pirinç, sadece besin değeri yüksek bir gıda maddesi değil, aynı zamanda cilt bakımında da birçok fayda sağlayan bir bileşendir. İşte pirinç sabununun cilde ve…
?⚕️ Somon Balığı Faydaları Nelerdir?
Somon balığı, sağlıklı beslenmenin önemli bir parçası olarak bilinir. Omega-3 yağ asitleri, protein, vitaminler ve mineraller açısından zengin olan bu lezzetli balık, birçok sağlık faydası sunar. İşte somon balığının sağlık açısından en önemli faydaları: 1. Kalp Sağlığını Destekler Somon, zengin…
?⚕️ Alp Tahlili Nedir? Alp Düşüklüğü, Yüksekliği!
Alkalin fosfataz (ALP), vücudumuzda birçok önemli işlevi olan bir enzimdir. Genellikle karaciğer, kemikler, böbrekler ve safra kanalları gibi organlarda bulunur. ALP tahlili, bu enzimin kanınızdaki seviyesini ölçerek sağlık durumunuzu değerlendirmeye yardımcı olur. Bu yazıda, ALP tahlilinin ne olduğu, yüksek ve…
?⚕️ Mchc Tahlili Nedir? Mchc Düşüklüğü, Yüksekliği!
Kandaki hücresel bileşenlerin sağlıklı işleyişi, vücut sağlığı açısından son derece önemlidir. Bu bağlamda, MCHC (Mean Corpuscular Hemoglobin Concentration) tahlili, kan testi sonuçları içinde önemli bir yer tutar. Bu yazıda MCHC tahlilinin ne olduğunu, düşüklüğü ve yüksekliğinin ne anlama geldiğini, örneklerle…
?⚕️ Aptt Kan Tahlili Nedir? Aptt Düşüklüğü, Yüksekliği!
APTT Nedir? APTT, “Activated Partial Thromboplastin Time” ifadesinin kısaltmasıdır. Türkçeye “Aktive Edilmiş Parsiyel Tromboplastin Zamanı” olarak çevrilebilir. Bu test, kanın pıhtılaşma süresini ölçen bir laboratuvar testidir ve genellikle koagülasyon (kan pıhtılaşma) bozukluklarını değerlendirmek için kullanılır. APTT Testinin Amaçları APTT testi,…
?⚕️ Folat Tahlili Nedir? Folat Düşüklüğü, Yüksekliği!
Folat, vücudun sağlıklı işlevlerini sürdürebilmesi için kritik öneme sahip bir B vitamini türüdür. Aynı zamanda folik asit olarak da bilinir ve hücre bölünmesi, DNA sentezi ve kırmızı kan hücresi üretimi gibi hayati süreçlerde rol oynar. Folat eksikliği, çeşitli sağlık sorunlarına…
?⚕️ Tahin Helvası Faydaları Nelerdir?
Tahin helvası, özellikle Türkiye ve Orta Doğu mutfaklarında yaygın olarak tüketilen besleyici bir tatlıdır. Susam tohumlarından elde edilen tahinle yapılan bu lezzetli helva, hem tatlı ihtiyacını karşılamakta hem de sağlığa birçok fayda sağlamaktadır. İşte tahin helvasının başlıca faydaları: 1. Zengin…